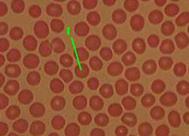
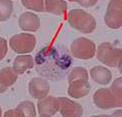

Многослойные покровные эпителии
| Определение | В многослойном эпителии с базальной мембраной связаны клетки только нижнего (базального) соя. | |
| Рис. 7.4. Эпителий мочевого пузыря Окраска гематоксилином и эозином | В мочевыводящих путях – переходный эпителий: при растяжении органа уплощается, т.е. переходит от одной формы к другой. У него – 3 слоя: - базальный (1), - промежуточный (2) и - поверхностный (3) из крупных клеток с округлыми ядрами. |

|
| Рис. 7.5. Передний эпителий роговицы Окраска гематоксилином и эозином | Это многослойный плоский неороговевающий эпителий. Он же – в полости рта и в пищеводе. В его составе условно выделяют тоже 3 слоя: - базальный (1), - шиповатый (2), чьи клетки содержат многочисленные «шипики», образующие десмосомы, и - наружный слойплоскихклеток. |

|
| Рис. 7.6. Эпителий кожи пальца (эпидермис) Окраска гематоксилином и эозином | Наконец, эпидермис - это многослойный плоский ороговевающий эпителий. В нём различают 5 слоёв: - базальный (1) – вместе с подлежащей базальной мембраной имеет очень извилистый контур из-за впячивания в эпителий многочисленных сосочков соединительной ткани; |

|
| - слой шиповатых клеток (2), - зернистый слой (3) – из уплощённых клеток (с уплощёнными же ядрами), заполненных гранулами т.н. кератогиалина, - блестящий (4) и роговой (5) слои – из безъядерных клеток, где кератин уже не образует гранулы, а занимает весь внутриклеточный объём в виде продольных плотно упакованных пучков. Таким образом, в ходе превращения базальных клеток в роговые чешуйки в них исчезают почти все органеллы и накапливаются промежуточные филаменты из белка кератина. Поэтому все эти клетки имеют общее название – «кератиноциты». |
6. Железистый эпителийа) Самая общая классификация желёз:
- по числу клеток – одноклеточные (напр., бокаловидные клетки) и многоклеточные;
- по направлению секреции – эндокринные (в кровь) и экзокринные (во внешнюю среду).
Дальше в этой теме речь будет идти лишь о многоклеточных экзокринных железах.
б) Общие сведения об экзокринных железах
| Компоненты желёз | 1) Концевые отделы – полые мешочки или трубочки, стенка которых состоит из экзокриноцитов, выделяющих в просвет свой секрет. 2) Выводные протоки – идут от концевого отдела к соответствующей полости тела или на его поверхность. Изнутри выстланы покровным эпителием. Замечание: в эндокринных железах нет ни концевых отделов, ни выводных протоков. | |||
| Типы секреции | 1) Меро-криновая секреция | Выделение секрета идёт без нарушения целостности экзокриноцитов. | Пример – слюнные железы. | |
| 2) Апо- криновая секреция | При выделении секрета происходит частичное разрушение апикальных отделов клеток. | Пример – молочные железы | ||
| 3) Голо-криновая секреция | Образуя секрет, клетки полностью разрушаются и выделяются вместе с секретом. | Пример – сальные железы | ||
| Природа секрета | По природе секрета железы делятся на 1) белковые, 2) слизистые, 3) белково-слизистые и 4) сальные | |||
| Морфоло-гическая класси-фикация желёз | 1) По ветвлению выводных протоков – | а) простые железы, если проток не ветвится б) сложные железы, если протоки ветвятся | ||
| 2) По ветвлению концевых отделов – | а) неразветвлённые и б) разветвлённые | |||
| 3) По форме концевых отделов – | а) трубчатые и б) альвеолярные | |||
7. Примеры желёз
| Рис. 7.7. Железы матки Окраска гематоксилином и эозином | Рис. 7.8. Сальные железы. Кожа с волосом Окраска гематоксилином и эозином | Рис. 7.9. Подчелюстная слюнная железа Окраска гематоксилином и эозином |

| 
| 
|
| Это простые неразветвлённые трубчатые железы | Это простые разветвлённые альвеолярные железы | А это сложные разветвлённые альвеолярно-трубчатые железы |
Тема 8. КРОВЬ
1. Ткани внутренней среды организма: общие свойства
Кровь (вместе с кроветворными и соединительными тканями) относится к тканям внутренней среды организма.
| а) Все эти ткани происходят из мезенхимы. б) Значительную часть объёма в каждой из них занимает межклеточное вещество: - жидкое (в крови и лимфе), - гелеобразное (в собственно соединительных тканях) или - твёрдое (в скелетных соединительных тканях). в) Клеточный состав многих (хотя не всех) этих тканей весьма разнообразен. |
2. Состав крови(общий объём у взрослого человека – около 5 л)
| Основные компоненты | а) Плазма (межклеточное вещество) – 55–60% объёма крови (~ 3 л). б) Форменные элементы – 40–45 % объёма крови. |
| Состав плазмы | а) Вода (90 % от массы) б) Белки (6,5–8,5% от массы): альбумины, глобулины, фибриноген в) Липиды – в составе специальных транспортных мицелл г) Многочисленные низкомолекулярные органические соединения д) Различные неорганические ионы |
| Форменные элементы | а) Эритроциты (красные кровяные тельца) – 5·1012 1/л б) Лейкоциты (белые кровяные тельца) – 6·109 1/л в) Тромбоциты (кровяные пластинки) – 2,5·1011 1/л |
3. Эритроцитыа) Морфология
| Зрелые эритро-циты | а) Эритроциты – постклеточные структуры, лишённые ядер и всех прочих органелл. Время жизни – 120 суток. б) По форме 85–90 % эритроцитов – двояковогнутые диски диаметром 7,5 мкм. в) На препарате окрашены эозином в розовый цвет, имеют округлую форму и просветление в центре. | Рис. 8.1. Эритроциты
Мазок крови
Окраска по Романовскому
Рис. 8.1. Эритроциты
Мазок крови
Окраска по Романовскому
|
| Ретикуло-циты | Около 1-2% эритроцитов крови составляют их непосредственные предшественники – ретикулоциты. | |
| При окраске по Романовскому неотличимы от зрелых эритроцитов. При окраске же мазка крезиловой синькой в ретикулоцитах выявляется зернисто-сетчатая структура – остатки органелл. | ||
| Старые формы | Около 9 % эритроцитов крови приходится на старые формы: - эхиноциты (эллипсоиды с шипами) – 6%, - сфероциты (сфероиды без шипов) – 1%, - стоматоциты (куполообразного вида) – 2%. |
б) Важнейшие белки эритроцитов
| Белки плазмолеммы | 1) Спектрин – образует на внутренней поверхности плазмолеммы сеточный каркас, придающий мембране эластичность и упругость. 2) Гликофорин – пронизывает всю мембрану и снаружи содержит группы (остатки сиаловой кислоты), придающие эритроциту существенный отрицательный заряд. 3) Анионные каналы – для Cl–, HCO3–, OH–. 4) Групповые антигены крови, в т.ч. антигены системы АВО. |
| Белок цитоплазмы – гемоглобин (Hb) | а) Занимает от четверти до половины объёма эритроцита. б) Молекулы содержат 4 белковые субъединицы; с каждой из них связан гем – вещество полициклической структуры с атомом Fe (II) в центре. в) Транспортирует в крови кислород – от лёгких к тканям. Каждый гем через атом Fe может связать одну молекулу О2. г) По аминокислотному составу различают несколько видов Hb. В частности, у гемоглобинаплода (HbF) сродство к кислороду выше, чем у гемоглобина взрослого человека (HbA). |
| Карбо-ангидраза | Тоже находится в цитоплазме эритроцитов. Облегчает перенос СО2 из тканей в лёгкие. – а) В тканях СО2 диффундирует из плазмы крови в эритроциты и превращается карбоангидразой в более растворимую форму (HCO3–), которая выходит в плазму и в таком виде транспортируется. б) В лёгких, наоборот, бикарбонат, «заходя» в эритроциты, превращается в СО2, который диффундирует из эритроцитов и вообще из крови – в выдыхаемый воздух. |
4. Лейкоцитарная формула– отражает разнообразие лейкоцитов и относительное содержание каждого их вида от общего количества лейкоцитов..
| I. ГРАНУЛОЦИТЫ,ИЛИ ЗЕРНИСТЫЕ ЛЕЙКОЦИТЫ | II. АГРАНУЛОЦИТЫ | |||||
| Нейтрофильные лейкоциты (нейтрофилы) | Эозино- филы | Базо-филы | Моно- циты | Лимфо- Циты | ||
| Юные | Палочко- ядерные | Сегменто- ядерные | Все виды | Все виды | ––––– | Все Виды |
| 0–0,5 % | 3–5 % | 65 –70 % | 2–4 % | 0,5– 1 % | 6–8 % | 20–30 % |
5. Гранулоцитыа) Общие свойства
| Ядра | а) У зрелых нейтрофилов и эозинофилов ядро – сегментированное: состоит из нескольких сегментов, связанных перемычками. б) Поэтому данные клетки (впрочем, как и базофилы, у которых ядро тоже слегка деформировано) к делению не способны. |
| Гранулы | Каждый гранулоцит содержит гранулы двух (или даже трёх) типов. а) Неспецифические (или первичные) гранулы – разновидности лизосом, почти одинаковые у всех гранулоцитов. б) Специфические (вторичные) – нейтрофильные, эозинофильные или базофильные – они-то и определяют вид гранулоцита. |
б) Нейтрофилы: размер – 10–15 мкм
| Ядро | 1) Зрелая форма – сегментоядерный нейтрофил: ядро – из 3–4-х сегментов. 2) Предшественник – палочкоядерный нейтрофил: ядро – ещё в виде изогнутой палочки. |
Рис. 8.2. Нейтрофилы:
сегментоядерный (слева) и
палочкоядерный (справа)
Мазок крови.
Окраска по Романовскому
Рис. 8.2. Нейтрофилы:
сегментоядерный (слева) и
палочкоядерный (справа)
Мазок крови.
Окраска по Романовскому
|
| Виды гранул | Гранулы – в виде мелкой зернистости. Три вида: - первичные (азурофильные), 15 %, - вторичные (нейтрофильные), 80%, - третичные, 5%. | |
| Содер- жимое гранул | В гранулах содержатся те или иные вещества из следующих групп. 1) Антимикробные белки и ферменты: - миелопероксидаза – окисляет ионы Cl– и I– в молекулы Cl2 и I2, которые, в силу высокой окислительной способности, убивают микробы; - лизоцим – разрушает полисахариды бактериальной стенки, - щелочнаяфосфатаза – расщепляет бактериальную ДНК, - лактоферрин – связывает необходимое для бактерий железо. 2) Ферменты, разрушающие межклеточное вещество в повреждённом участке ткани: эластаза, коллагеназа, желатиназа. | |
| Плазмо-лемма | В плазмолемме – рецепторы - к некоторым бактериальным поверхностным белкам и гликолипидам, - к олигосахаридам собственных клеток, выходящим на поверхность при повреждении клеток, - к неспецифической области иммуноглобулинов G (IgG). | |
| Функция | 1) Нейтрофилы мигрируют из крови в очаг повреждения ткани, где - могут «дистантно» поражать бактерии – выделяя антимикробные в-ва, - но, главное, фагоцитируют бактерии и «тканевые обломки» – благодаря перечисленным рецепторам. Поэтому нейтрофилы называют микрофагами. 2) Часть нейтрофилов может в результате фагоцитоза тоже погибать. Смесь погибших нейтрофилов, убитых бактерий и разрушенных остатков ткани составляет гной. |
в) Базофилы: размер – 9–12 мкм
| 1. В крови 1 базофил приходится примерно на 100.000 эритроцитов. 2. Ядро – слабодольчатое и трудноразличимое за крупными базофильными гранулами, заполняющими почти всю цитоплазму. 3. Среди прочих веществ эти гранулы содержат: - гистамин – медиатор воспаления (расширяет сосуды и повышает их проницаемость); образуется из аминокислоты гистидина; - и гепарин – полисахарид с противосвёртывающей активностью. 4) На плазмолемме базофилов – рецепторы к свободным IgE. Если же связывается ещё и антиген, содержимое гранул высвобождается и развивается воспалительная или даже аллергическая реакция. |
 Рис. 8.3.
Базофил
Мазок крови
Рис. 8.3.
Базофил
Мазок крови
|
г) Эозинофилы: размер – 12–17 мкм
| Морфология | 1) Ядро состоит из 2-х сегментов. 2) Эозинофильные гранулы содержат: - главный оснóвный белок, обладающий антипаразитарной (антигельминтной и антипротозойной) активностью, - фермент гистаминазу, инактивирующий гистамин. |
 Рис. 8.4.
Эозинофил
Мазок крови
Окраска
по Романовскому
Рис. 8.4.
Эозинофил
Мазок крови
Окраска
по Романовскому
|
| Функция | Соответственно, функции эозинофилов таковы: 1) противопаразитарная защита, 2) уравновешивание действия базофилов, т.е. противовоспалительное и антиаллергическое действия – за счёт целой серии антигистаминных эффектов: эозинофилы | |
| - тормозят освобождение гистамина из базофилов, - а тот гистамин, который уже выделился, адсорбируют на своей поверхности, фагоцитируют и инактивируют в эозинофильных гранулах. |
6. Агранулоциты. Моноциты:размер – 18–20 мкм
| Морфо-логия | 1) По размеру моноциты – самые крупные среди форменных элементов крови. 2) Ядро – тоже крупное, бобовидное (нередко – вообще неправильной формы) и относительно светлое. 3) Цитоплазма – в виде светлого широкого ободка и может содержать несколько гранул. |
 Рис. 8.5.
Моноциты
Мазок крови
Окраска
по Романовскому
Рис. 8.5.
Моноциты
Мазок крови
Окраска
по Романовскому
|
| Функции моноцитов | Единственная функция моноцитов состоит в том, что в тканях они превращаются в макрофаги. Причём, имеется около десятка разных видов макрофагов: I. типичные макрофаги, II. остеокласты - в костной ткани, и т.д. Все они происходят из моноцитов крови. | |
| Отличие макрофага от моноцита | В ходе превращения моноцита в макрофаг - увеличивается размер клеток, - в клетках накапливаются лизосомы и компоненты белоксинтезирующей системы, - на поверхности появляются новые рецепторные белки.. | |
| Функции макрофагов | Макрофаги – активные участники иммунных и воспалительных реакций. При этом среди их функций наиболее важны следующие три. 1) Фагоцитоз: происходит примерно так же, как у микрофагов (т.е. с участием рецепторов плазмолеммы и затем – активных окислителей). 2) Представление антигенных детерминант (небольших пептидов из разрушенных белков) Т-лимфоцитам, без чего последние не могут опознать антиген. 3) Секреция многочисленных биологически активных веществ. |
Дата добавления: 2015-08-04; просмотров: 1257;
